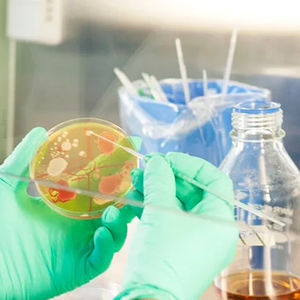
Laboratory work at the School of Chemical Engineering

Unite! Engineering Biology matchmaking event (online)
When
Where
Event language(s)
In the dynamic world of biotechnology, biosciences, and chemistry, Unite! fosters collaboration and innovative networking as it drives joint proposal initiatives through an upcoming online matchmaking event to help us move towards a net-zero society.
Biotechnology and Synthetic Biology are key to developing sustainable processes that use carbon dioxide and biomass as future resources across many industries. The upcoming online matchmaking event serves as a platform for scientific exchange and collaboration among Unite! researchers specializing in biotechnology, biosciences, and chemistry.
How to participate?
We invite participants to present their activities and recent research highlights in short 10-minute presentations, followed by discussions. Breakout sessions will facilitate networking and collaboration opportunities for those interested in launching Unite! seed fund proposals and other initiatives.
Researchers interested in participating are invited to submit a short abstract of their research (max. 200 words) and references to molbiotech.unite@tugraz.at by August 15, 2024.
Practical information
- Date and time: September 11, 2024 from 10:00 -18:00, organized online
- Registration: Please submit a short abstract with a project title (max. 200 words) and references to molbiotech.unite@tugraz.at
- Registration deadline: August 15, 2024.
- For more information, contact molbiotech.unite@tugraz.at
The team behind the matchmaking initiative includes members such as Robert Kourist from TU Graz, Christian Schnepel and Per Berglund from KTH, Heribert Warzecha from TU Darmstadt, and Lukasz Berlicki from Wroclaw Tech.
Unite! universities
- Graz University of Technology, Austria
- Kungliga Tekniska Högskolan, Sweden
- Universitat Politècnica de Catalunya, Spain
- Universidade de Lisboa, Portugal
- Technische Universität Darmstadt, Germany
- Politecnico di Torino, Italy
- Institute Polytechnique de Grenoble, France
- Wroclaw University of Science and Technology, Poland
- Aalto University, Finland
Unite! University Alliance
Aalto University is a member of Unite! alliance together with eight other European universities.







